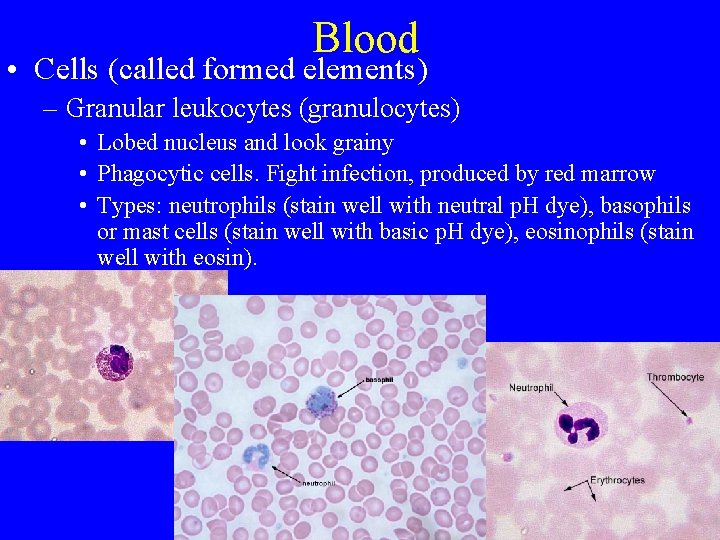
Blood • Cells (called formed elements) – Granular leukocytes (granulocytes) • Lobed nucleus and
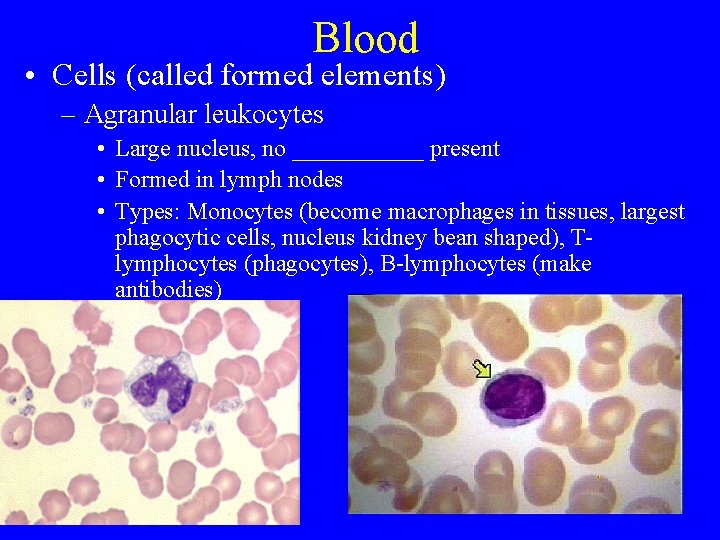
Blood • Cells (called formed elements) – Agranular leukocytes • Large nucleus, no ______

Respiratory System Respiratory System Organs concerned with exchange

- Slides: 63
Respiratory System
Respiratory System • Organs concerned with exchange of gases between animal and environment • Not ______ respiration (glucose broken down to make ATP)
Respiratory System • External respiration: exchange of gases between air in lungs and blood • Internal respiration: exchange of gases between blood and body tissues
Respiratory System • Divisions of respiratory system – Upper respiratory system: Nose, throat and trachea – Lower respiratory system: Lungs (bronchi, bronchioles, alveoli)
Respiratory System • Upper respiratory system – External nares (nostrils) – Nasal cavity: contains nasal turbinates (paper thin bones). Covered with mucous membranes. Functions: warm and humidify air, filter air (dust particles, etc. )
Respiratory System • Upper respiratory system – Nasopharynx: contains tonsils. ____ tissue. Used to protect respiratory system from airborne infections, but not vital (often removed).
Respiratory System • Upper respiratory system – Larynx: voicebox. Vocal cords: bands of connective tissue that _____ when air passed over them – Neck, cheek, mouth and tongue form sounds into words.
Respiratory System • Lower respiratory system – Trachea – Bronchus (left and right) – Bronchioles – Alveolar sacs – Alveoli
Respiratory System • Lower respiratory system – Diaphagm (only in mammals): made of muscles and tendons – Pleural cavity (partial ______) – Intercostal muscles (between ribs)
• Inhalation Respiratory System – 1) Intercostal muscles contract (ribcage raises) – 2) Diaphragm contracts (moves downward) – 3) Volume of pleural cavity increases – 4) Internal lung pressure decreases – 5) Air enters lungs
• Exhalation Respiratory System – 1) Intercostal muscles relax (ribcage lowers) – 2) Diaphragm relaxes (moves upward) – 3) Volume of pleural cavity decreases – 4) Internal lung pressure increases – 5) Air leaves lungs
Respiratory System • Sucking chest wound (not the song) – Pleural cavity unsealed – Lung collapses as air pressure difference between chest cavity and outside kept constant by wound (air flows in and out of wound)
Respiratory System • Gas transport: overall plan – 1) Heart pumps low oxygen blood to lungs – 2) Oxygen in and carbon dioxide out – 3) Blood returns to heart and is pumped to body – 4) Oxygen out of blood and carbon dioxide in
Respiratory System • Gas transport – Oxygen non-polar: not very _____ in water – Hemoglobin: protein that binds with oxygen. Contains Fe in each chain, which binds oxygen.
Respiratory System • Red blood cell or rbc (ethrythrocyte) contains 300 million hemoglobin molecules. Each molecule binds to 4 oxygen molecules. 1200 million oxygen molecules on 1 rbc!
Respiratory System • Carbon dioxide transported in 3 ways: – 1) Dissolved in plasma (_______% of CO 2) as bicarbonate (HCO 3 -). – CO 2 + H 2 O forms H 2 CO 3 which forms H+ and HCO 3– This also affects p. H of blood. More CO 2 means lower blood p. H.
Respiratory System • Carbon dioxide transported in 3 ways: – 2) Bound to hemoglobin (25%). Binds to amino acids, not to Fe. – 3) Dissolved in plasma as CO 2 (8%).
Respiratory System • Control of breathing: – Brain stem center monitors blood p. H – If p. H drops, then too much CO 2 in blood – Breathing rate _______ in response.
Circulatory System
Circulatory System • Functions: – 1. Transport of materials (gases, nutrients, wastes) – 2. Temperature regulation
Circulatory System • Functions: – 1. Transport of materials (gases, nutrients, wastes) – 2. Temperature regulation – 3. Carries _______ hormones – 4. Protection (immune defense, blood clotting)
Circulatory System • Types in animals: – None! Phylum Platyhelminthes, Nematoda, Echinodermata, etc. Circulation can occur (ex, nematodes) due to body movements.
Circulatory System • Types in animals: – Open. Phylum Arthropoda, Mollusca. No capillaries: have _____ into which blood flows from vessels.
Circulatory System • Types in animals: – Closed. Phylum Annelida, Chordata. Blood always stays in vessels as it circulates.
• Vessels: Circulatory System – Arteries (carry blood away from heart): large diameter – Thick elastic muscular walls. Can handle high blood pressure – Connective tissue sheath outside, endothelium inside.
Circulatory System • Vessels: – Arterioles (carry blood away from heart): small diameter (microscopic) – Smooth muscle controls blood flow. Vasoconstriction is contraction to cut flow down – Vasodilation is relaxation to increase flow.
Circulatory System • Vessels: – Precapillary sphincters: smooth muscle valves on some arterioles near capillaries. Can cut off blood flow – Important: most capillaries not open simultaneously (blood pressure would ______ critically). Parts take turns.
Circulatory System • Vessels: – Capillaries: very small diameter (8 micrometers: rbc only 5 -7 micrometers wide). Where most exchange of materials takes place – Every cell in body within 100 micrometers of a capillary! – 250, 000 capillaries in area size of little fingernail
Circulatory System • Vessels: – Capillaries connect arteriole to venule – No smooth muscle, just endothelium (note diagram in error: capillary on upper right)
• Vessels: Circulatory System – Venules (carry blood toward heart): small diameter (microscopic) – Smooth muscle thin. Pressure low (_____% of arteries). Connective tissue sheath outside, endothelium inside – Veins (carry blood toward heart): large diameter Note: labels for vein and capillary are reversed in diagram
Circulatory System • Vessels: – Veins often have one-way valves. Muscle contractions can help move blood through valves
Circulatory System • Vessels: – Varicose veins: weakened valves in legs allow backflow. Small veins bulge with venous blood.
Circulatory System • Lymphatic system: open circulatory system
Circulatory System • Blood plasma fluid in tissues (interstitial fluid) bathes tissues. Not all returns to blood capillaries • Lymphatic capillaries, vessels, nodes, organs • Capillaries collect _____ (lymph) and pass to larger vessels
Circulatory System • Lymphatic system vessels: little smooth muscle in walls • Have series of one-way valves. Fluid moves mainly due to _______ of nearby skeletal muscles Fluid moves left to right here
Circulatory System • Lymph system functions • 1) Drain excess fluid from tissues (recall elephantiasis, where nematodes clog system)
Circulatory System • Lymph system functions • 2) Involved in fat absorption from ______ (covered)
Circulatory System • Lymph system functions • 3) Fights infection at lymph nodes (about 100 in human body) – Bean shaped, various places.
Circulatory System • Lymph system functions • 3) Produce B- and T-lymphocytes. These produce antibodies that detect foreign materials (ex, bacteria) – Nodes become _______ in areas downstream of infection as lymphocytes attack invaders
Heart • Major organ of circulatory system • Enclosed in membrane called pericardium • Pumps blood into arteries.
Heart • Humans (vertebrates in general) have 4 chambered heart that functions in 2 sets of 2 chambers • Chambers called _____ receive blood, pump it into more muscular chambers called ventricles, which send blood away from heart.
Heart • One set receives deoxygenated blood and sends it to lungs (pulmonary circulation) – Right atrium (receives deoxygenated blood) from superior (from head) and inferior (from lower body) vena cava arteries – Right ventricle (pumps it to lungs) via pulmonary _____.
Heart • Second set receives oxygenated blood from lungs and sends it to body (systemic circulation) – Pulmonary vein brings oxygenated blood to left atrium – Left ventricle pumps oxygenated blood to body via _____.
Heart • Note valves: prevent backflow of blood when chamber contracts • Tricuspid valve: between right atrium and ventricle • Bicuspid valve: between left atrium and ventricle
Heart • Note valves: prevent backflow of blood when chamber contracts • Semilunar valves (aortic and pulmonary): between ventricles and arteries that receive blood from them.
Heart • Chordae tendinae and papillary muscles keep bicuspid and tricuspid valves ______.
Heart • Beating controlled by special groups of cardiac muscle cells (called nodes) that generate impulse • Other cells then transmit impulse to one another via intercalated discs.
Heart • SA node (right atrium) originates beat • Causes ____ to contract (ventricle relaxed at this time).
Heart • AV node receives stimulus • Sends to ventricle cells through specialized cardiac muscle cells called Purkinje fibers • Ventricle cells then contract (after atria relax)
Heart • Heart sound: Lub-dub • Lub: biscuspid and tricuspid valves closing as ventricles contract • Dub: aortic and pulmonary semilunar valves closing as ventricles re-fill
Heart • Autonomic nervous system influences heartbeat rate – Sympathetic nerves: accelerate – Parasympathetic nerves: slow rate – Some hormones (ephinephrine = adrenalin): _______ rate.
Blood • Connective tissue: cells in matrix • Matrix: plasma.
Blood • Plasma components: – 1. Water (______%) – 2. Salts (Ca, K, Na) – 3. Proteins • globulins: large immunoglobins (antibodies) • albumins: osmoregulation (most abundant blood protein) • fibrinogen: helps clotting. Serum is plasma minus fibrinogen – – – 4. Glucose (regulated by glucagon and insulin) 5. Glycerol and fatty acids 6. Hormones 7. Urea (nitrogenous waste) 8. Carbon dioxide and bicarbonate
Blood • Cells (called formed elements) – Erythrocytes (red blood cells: rbcs): no nucleus, biconcave disc shape, flexible. Origin: red bone marrow
Blood • Cells (called formed elements) – Leukocytes (white blood cells: wbcs): have nucleus. <___% of blood cells
Blood • Cells (called formed elements) – Granular leukocytes (granulocytes) • Lobed nucleus and look grainy • Phagocytic cells. Fight infection, produced by red marrow • Types: neutrophils (stain well with neutral p. H dye), basophils or mast cells (stain well with basic p. H dye), eosinophils (stain well with eosin).
Blood • Cells (called formed elements) – Agranular leukocytes • Large nucleus, no ______ present • Formed in lymph nodes • Types: Monocytes (become macrophages in tissues, largest phagocytic cells, nucleus kidney bean shaped), Tlymphocytes (phagocytes), B-lymphocytes (make antibodies)
Blood • Cells (called formed elements) – Thrombocytes (platelets) • No nucleus. Fragments of red bone marrow cells • Function in clotting of blood.
Blood Summary • Cells (called formed elements) – Thrombocytes (platelets) • No nucleus. Fragments of red bone marrow cells • Function in clotting of blood
Blood Clotting • Blood vessel wall broken • Platelets stick to each other and to break. Release______ factors.
Blood Clotting • Protein called prothrombin converted to thrombin, which causes fibrinogen in plasma to become fibrin (protein threads) • These threads bind together platelets and blood cells to make clot.
How Phagocytic WBCs work • • Damage to tissues Mast cells release _____ Causes blood vessels to dilate Increases permeability of capillaries.
How Phagocytic WBCs work • Neutrophils and monocytes stick to lining of capillary • Squeeze through wall into tissue • Locate and ____ invading cells.